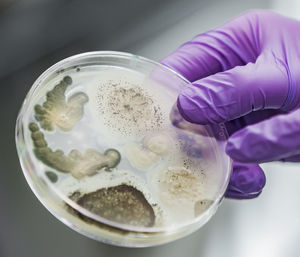
Bioscience research in a laboratory

Petri Dish

Side view of young man sitting on table

Rear view of woman standing against sky

Biomass energy research conducted in laboratory

Portrait of boy standing against yellow background

Full frame shot of bubbles in water

Man working on table

Scientist lifting seedling with tweezers and looking through magnifying glass

Biomass energy research conducted in laboratory

Female doctor working in hospital

Hand holding seedling on petri dish

Close-up of glasses on table

Midsection of scientist working in laboratory

Scientist with petri dish examining medical sample through microscope

Female doctor working in hospital

Midsection of scientist doing experiment on desk

Flask glassware in science laboratory.

Cropped hand of boy examining plant at laboratory

Cropped hand holding petri dish by test tubes in laboratory

Bioscience research in a laboratory

Close-up of fern leaves

Close-up of boy drinking water

Scientist holding petri dish tray while standing at laboratory

Close-up of man holding leaf in petri dish

Lab technician experimenting in lab

Male doctor discussing with coworkers in hospital

Pipetting of sample into petri dish containing cell micrograph

Close-up of scientist examining petri dish

Scientists experimenting with chemicals on table in laboratory

Full frame shot of frozen ice

Biomass energy research conducted in laboratory

Scientist examining samples in petri dish under microscope at laboratory

Midsection of man working

Pipetting of sample into petri dish

Anti-aging cosmetics and collagen powder in a petri dish on a beige background and green leaves.

Portrait of young man standing against plants

Close-up of water drops on leaf

Laboratory assistant filling liquid in multi well plate at laboratory

Midsection of person holding ice cream

Pipetting sample into tray for dna testing with result in background

Rear view of man sitting at window

Rear view of scientist working at lab

Seedling on petri dish in laboratory

Scientist lifting seedling with tweezers

Nuclear transfer being carried out on several embryonic stem cells

Scientist in lab holding grain sample in petri dish

Low angle view of woman sitting on mountain against clear blue sky

Close-up of scientist holding petri dish

Portrait of a young woman

Close-up of wet spider web during winter

Full frame shot of green leaves

Female doctor working in hospital

Mature man reading book seen through plants

Close-up of hand holding wine glasses

Scientist in protective suit working over chemical at laboratory

Hand holding seedling on petri dish

Scientist hand holding petri dish tray while standing at laboratory

Home of the bee family

Hand holding seedling on petri dish

Ph measurement in lab

Scientist looking at seedlings through magnifying glass

Portrait of young man wearing sunglasses standing outdoors.

High angle view of machinery

Lab technician preparing sample

Cropped image of surgeon holding medical sample

Hand holding seedling on petri dish

Close-up of scientist holding petri dish in laboratory

Full frame shot of green leaves

Young man wearing sunglasses against sky

Cropped hand of scientist holding multiwell tray containing stem cells while working in laboratory

Pipetting of sample into petri dish containing cell micrograph

Man working against blue sky
Bioscience research in a laboratory

Lab technician working with machine in lab

Close-up of hand holding plant

Scientist wearing protective glove holding fungal cultures in petri dish

Biomass energy research conducted in laboratory

Close-up portrait of a woman

Lab technician working with machine in lab

Petri dish with embryonic stem cells used in cloning and genetic modification

Bioscience research in a laboratory

Close-up of scientist examining samples in petri dish at laboratory

Scientist analyzing cultured artificial meat sample under the microscope in laboratory

Mold samples on white background. a petri dish with colonies of microorganisms

Anti-aging cosmetics. collagen powder and hyaluronic acid in petri dishes, cosmetic bottles

Close-up of glass jar on table against white background

High angle view of man working at workshop

Close-up of vials by petri dish against white background

Hands in blue gloves hold a petri dish with a plant and tweezers

Close-up of jellyfish

Scientist lifting seedling with tweezers

Rear view of man standing on field against clear sky

Plants growing in greenhouse

High angle view of leaves in plate on white background

Midsection of scientist with petri dish on table in laboratory

Cropped image of scientist doing experiment in petri dish

Mature female medical expert using tweezers while analyzing medical samples through microscope in lab

Mold samples on white background. a petri dish with colonies of microorganisms

Girls learning science and using a professional microscope

Midsection of person working

Young female scientist experimenting at lab